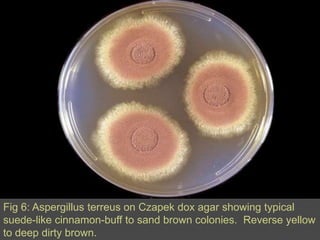
Fig 5: Microscopic morphology of Aspergillusniger showing large, globose, dark brown conidial heads, which become radiate, tending to split into several loose columns with age.  Conidiophores are smooth-walled, hyaline or turning dark towards the vesicle.  Conidial heads are biseriate with the phialides borne on brown, often septatemetulae. Conidia are globose to subglobose, dark brown to black and rough-walled.

A 50-year-old man with a history of end-stage renal disease and diabetes underwent a kidney transplant. He later developed a nonproductive cough. Additional testing showed a new lung lesion and biopsy revealed Aspergillus fungus. Invasive pulmonary aspergillosis was diagnosed. Treatment guidelines recommend the antifungal drug voriconazole as the primary treatment, with alternative options including other antifungals depending on the patient's condition and test results.